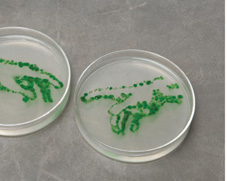

Tổng hợp được tế bào sống đầu tiên
Craig Venter, nhà khoa học say mê giải mã gene, lại một lần nữa làm rúng động giới khoa học khi nhóm nghiên cứu của ông tuyên bố thành công trong việc tạo ra tế bào sống tổng hợp đầu tiên.
Cấy bộ gene tổng hợp vào vi khuẩn
Craig Venter theo đuổi giấc mơ của mình trong suốt 15 năm: xây dựng bộ gene từ đống hợp chất vô cơ và sử dụng chúng để tạo ra sự sống nhân tạo. Mới đây ông và nhóm nghiên cứu tại Viện Craig Venter nói họ đã thực hiện được giấc mơ này. Dưới đây là câu chuyện họ tường thuật lại các bước tạo ra nhiễm sắc thể vi khuẩn nhân tạo và quá trình chuyển thành công nhiễm sắc thể này thành vi khuẩn sống, để có thể thay thế cho DNA nguyên bản. Sau khi được cấy vật chất di truyền mới, tế bào nhân tạo của vi khuẩn bắt đầu nhân lên và tạo ra hàng loạt protein mới.
“Đây là một sự kiện quan trọng trong lịch sử sinh học và công nghệ sinh học”, Mark Bedau, nhà triết học tại Reed College, Portland, Oregon và là biên tập viên của tạp chí khoa học Artificial Life (Sự sống nhân tạo) nói. Bộ gene tổng hợp do nhóm Venter tạo ra khá giống với của bộ gene của vi khuẩn tự nhiên. Để đi đến thành công, 20 người trong nhóm làm việc đã phải lao động cật lực trong suốt hơn một thập kỷ, với một khoản tài chính vào khoảng 40 triệu USD. Mặc dầu vậy, để tạo ra những bộ gene thực sự như các loại bộ gene sống chuyên tạo ra năng lượng, dược phẩm, và khiến chúng sống được trong các tế bào hiện vẫn là điều chưa thể thực hiện được.
Xuất phát từ một dự án của Venter và các cộng sự, vi khuẩn tổng hợp vừa được công bố cho phép xác định các điều kiện tối thiểu cần có cho sự sống của loài này. Từ đó, các nhà khoa học có thể thêm vào các gene khiến các vi khuẩn có thể tạo ra các hợp chất hữu ích cho con người. Vào năm 1995, nhóm đã nghiên cứu vi khuẩn Mycoplasma genitalium có khoảng 500 gene và các nhà nghiên cứu thấy rằng họ có thể loại bỏ 100 gene mà không gây ra phản ứng gì.
Nhưng để bộ gene tối thiểu có thể tồn tại cần phải tổng hợp nhiễm sắc thể hoàn chỉnh và làm cho nó có thể hoạt động trong tế bào tiếp nhận bộ gene này. Hai bước này đã phải thực hiện trong nhiều năm vì chưa có công nghệ tạo ra và xử lý toàn bộ nhiễm sắc thể. Vào năm 2007, Venter, Smith, Hutchison và đồng nghiệp cuối cùng đã chỉ ra rằng họ có thể thay thế các nhiễm sắc thể tự nhiên từ một loại vi khuẩn này sang một loài khác. Vào năm 2008, họ đã chỉ ra có thể tạo ra nhiễm sắc thể nhân tạo tương thích với M. genitalium đồng thời chứa các chuỗi DNA có những dấu hiệu giúp cho việc phân biệt bộ gene tổng hợp và bộ gene tự nhiên.
Nhưng việc kết hợp các bước này không mang lại kết quả, một phần vì M. genitalium lớn chậm thành thử phải mất vài tuần để hoàn thiện. Nhóm nghiên cứu quyết định thay bằng vi khuẩn M. mycoides lớn nhanh hơn và bắt đầu tạo nên bản tổng hợp nhiễm sắc thể của nó. Năm ngoái, họ đã chỉ ra họ có thể tách nhiễm sắc thể tự nhiên của M. mycoides và đặt nó vào trong vi khuẩn lên men, làm biến đổi bộ gene của vi khuẩn, sau đó chuyển nó sang M. capricolum. Bước tiếp theo của nghiên cứu cho thấy bản tổng hợp DNA của vi khuẩn có thể làm bằng cách tương tự.
Các nhà nghiên cứu bắt đầu xây dựng các nhiễm sắc thể tổng hợp bằng lựa chọn DNA trong ngân hàng dữ liệu. Họ ghép 10.000 đoạn DNA lại với nhau, rồi sau đó là 100.000 đoạn, cuối cùng là hoàn thiện bộ gene. Tuy nhiên, khi họ đưa bộ gene tổng hợp vào M. capricolum, không có điều gì xảy ra giống như các nhà lập trình máy tính đụng phải các phần mềm giả, sau đó họ đã thay thế 1 cách có hệ thống các DNA tự nhiên và tổng hợp, và cuối cùng phát hiện ra lỗi trong bộ gene tổng hợp. Lỗi này đã làm chậm tiến độ của dự án 3 tháng.
Sau nhiều tháng thay thế nhiều đoạn gene kết hợp không thành công, may mắn đã đến với nhóm trong tháng vừa qua khi nhà sinh vật tìm thấy một nhóm màu xanh của vi khuẩn lớn rất nhanh trên đĩa thí nghiệm. (Màu xanh chỉ ra rằng tế bào đã sử dụng bộ gene mới). Nhóm nghiên cứu khẳng định rằng vi khuẩn có gene tổng hợp và sau khi kiểm tra cho thấy các vi khuẩn tạo thành protein đặc trưng của loại M. mycoides.
“Kết quả thật là ấn tượng”, Anthony Forster, nhà sinh học phân tử tại Đại học Vanderbilt, Tennessee nói. Tuy nhiên ông này và một số người khác cho rằng Venter vẫn chưa tạo ra được dạng sự sống tổng hợp vì bộ gene đã được cấy vào tế bào sống.
Theo một số nhà nghiên cứu, kỹ thuật mà nhóm Venter sử dụng rất khó để các nhóm khủng bố sinh học sử dụng. “Tuy nhiên, thí nghiệm này sẽ làm thay đổi tưởng tượng của chúng ta về cách sự sống được tạo ra lâu nay”, Paul Rabinow nhà nhân chủng học tại Đại học California, Berkeley nói. Theo Kenneth Oye, nhà khoa học xã hội tại MIT, thành công của Craig Venter như phát súng bắn vào màn đêm, mang tới những lợi ích và cả những rủi ro tiềm ẩn trong tương lai.
Theo một số nhà nghiên cứu, kỹ thuật mà nhóm Venter sử dụng rất khó để các nhóm khủng bố sinh học sử dụng. “Tuy nhiên, thí nghiệm này sẽ làm thay đổi tưởng tượng của chúng ta về cách sự sống được tạo ra lâu nay”, Paul Rabinow nhà nhân chủng học tại Đại học California, Berkeley nói. Theo Kenneth Oye, nhà khoa học xã hội tại MIT, thành công của Craig Venter như phát súng bắn vào màn đêm, mang tới những lợi ích và cả những rủi ro tiềm ẩn trong tương lai.
“Sự sống nhân tạo gần như trong tầm tay của con người, các cơ quan hữu trách phải thiết lập khung pháp lý nhanh chóng vì không loại trừ khả năng sử dụng sai mục đích các kết quả nghiên cứu”, Oye nói thêm.
Venter nói rằng Viện nghiên cứu mang tên ông đã nộp đơn xin cấp một vài bằng sáng chế thuộc quyền sở hữu của công ty Synthetic Genomics, đơn vị đã cung cấp kinh phí cho dự án. Cơ quan giám sát về công nghệ ETC tại Ottawa cho rằng những việc làm này sẽ dẫn tới sự độc quyền trong việc sản xuất ra sự sống nhân tạo. Nhưng một số nhà nghiên cứu khác thì cho rằng, Synthenic Genomics rất khó trở thành Microsoft trong lĩnh vực sinh học tổng hợp. Tuy nhiên, có một điều chắc chắn là một vài sáng tạo thú vị sẽ bắt nguồn từ phòng thí nghiệm của Viện Venter.
Craig Venter – người say mê giải mã
Craig Venter, sinh năm 1946, không thuộc tuýp học trò chỉ biết có học tập. Sau khi bỏ ngang trung học vào những năm 1960, ông dành thời gian lướt ván ở miền nam California trước khi bị tuyển vào quân đội. Hy vọng được tập luyện để tham gia vào Olympic trong đội hình bơi của hải quân tan thành mây khói khi Tổng thống Lyndon B. Johnson quyết định tiến hành chiến tranh leo thang tại Việt Nam. Venter bị điều động sang Việt Nam, và trải qua 6 tháng khó quên tại Đà Nẵng, nơi ông từng phải thức trắng đêm để khâu vết thương cho những người bị thương tại một bệnh viện của Đà Nẵng trong đợt tấn công Tết Mậu Thân năm 1968.
Làm việc trong môi trường gần cái chết trong giai đoạn chiến tranh Việt Nam đã làm cho Venter mong muốn được học về Y học. Venter đăng ký học hóa sinh và hoàn thành chương trình tiến sĩ về sinh lý học và dược học năm 1975 tại Đại học California, San Diego.
Sau thời gian làm giáo sư tại Đại học New York, Buffalo, Venter thành lập nhóm nghiên cứu của mình vào năm 1984 tại Viện Y tế quốc gia Hoa Kỳ (NIH). Ông đã phát minh ra kỹ thuật giải mã gene nhanh – kỹ thuật ESTs, được phát triển ngay chính phòng thí nghiệm của mình tại NIH và muốn xin cấp bằng sáng chế. Nhiều nhà khoa học nổi tiếng, bao gồm cả giám đốc chương trình gene người vào thời kỳ đó là James Watson, đã phản đối ý định đăng ký sáng chế đối với kỹ thuật này vì cho rằng nó sẽ làm tổn hại mối quan hệ hợp tác giữa các nhà nghiên cứu.
Venter rời NIH vào năm 1992 vì cảm thấy mình bị đối xử bất công. Ông không giấu sự tức giận vì những người trong Viện đã không thừa nhận đề xuất phương án giải mã gene vi khuẩn H. influenzae của ông. Sau khi không xin được tài trợ của NIH cho dự án của mình, Venter từ chối một vài lời mời từ các công ty công nghệ sinh học trước khi chấp nhận 70 triệu USD tài trợ từ Tập đoàn HealthCare Investment để thành lập Viện nghiên cứu gene (The Institute for Genomic Research), nơi ông có thể tiếp tục công việc giải mã gene của mình.
Năm 1995, Venter công bố đoạn gene đầu tiên đầy đủ của một sinh vật sống, vi khuẩn Haemophilus influenzae, loại vi khuẩn gây ra bệnh viêm màng não và điếc. Tiếp đó, năm 1998 ông nhận được toàn bộ khoản tiền tài trợ tư trị giá 300 triệu USD cho dự án giải mã gần 3 tỷ đơn vị hóa học tạo nên bộ gene người. Trong những năm 2007 và 2008, Venter liên tục xuất hiện trên các tạp chí lớn với những công bố mới về giải mã gene. Ông được tạp chí Time bình chọn là 1 trong 100 người có ảnh hưởng nhất thế giới.
